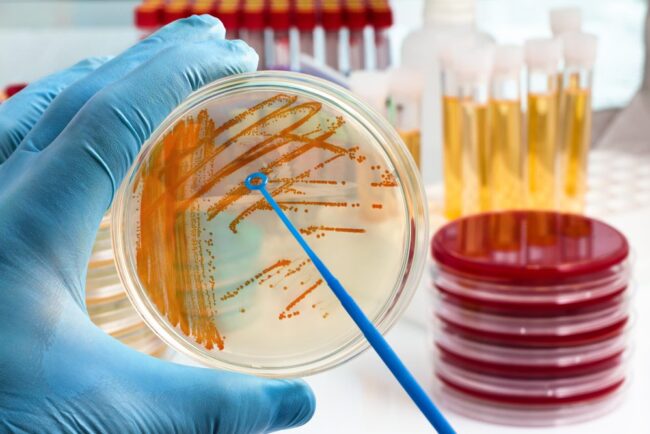

HB ELECTROPHORESIS
WHAT IS HB ELECTROPHORESIS TEST? HB electrophoresis is also referred to as a sickle cell screen or hemoglobin evaluation test. Hemoglobin is a different type of protein in your red blood cells, which is being measured through the HB electrophoresis test. Inside red blood cells hemoglobin is present that is capable of transferring oxygen to…